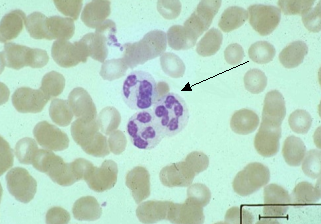

| Скачать .docx | Скачать .pdf |
Реферат: Нейтрофилы
Создана и реализована, в виде компьютерной программы, математическая модель движения популяции клеток. Показано, что широко принятое в литературе деление нейтрофилов на медленные, средние и быстрые следует считать условным. Экспериментальные измерения скоростей нейтрофилов в популяции распределены непрерывно. Модель подвергает сомнению широко принятое мнение о существовании памяти нейтрофилов. Экспериментальные данные хорошо описываются в рамках марковской модели. Наблюдаемое в эксперименте закономерное возвращение некоторых нейтрофилов к начальной точке связано только с недостатком статистики для измерения среднеквадратичного отклонения на больших временах.
Содержание
Аннотация_________________________________________________________ 1
Введение____________________________________________________________ 3
Физиология нейтрофилов____________________________________________ 5
Общая характеристика_____________________________________________ 5
Рецепторы в плазматической мембране________________________________ 8
Механизмы активации нейтрофилов__________________________________ 9
Подвижность нейтрофилов_________________________________________ 13
Методы исследования подвижности нейтрофилов______________________ 17
Алгоритм работы модели клетки____________________________________ 22
Вычисление координат клетки______________________________________ 24
Генерация случайных чисел с заданным распределением (Монте-Карло)__ 25
Программная реализация алгоритма_________________________________ 28
Процедура редактирования распределений___________________________ 31
Измерение среднеквадратичного отклонения__________________________ 33
Результаты исследования___________________________________________ 34
Измерение пройденного пути_______________________________________ 36
Исследование зависимости среднеквадратичного отклонения от времени наблюдения 43
Заключение________________________________________________________ 49
Выводы__________________________________________________________ 52
Список литературы________________________________________________ 53
Приложение_______________________________________________________ 55
Текст программы математического моделирования случайного блуждания популяции нейтровилов______________________________________________________ 55
В настоящее время подвижность нейтрофилов рассматривается, как очень важный показатель физиологического состояния лейкоцитов в борьбе с инфекцией. С нарушением подвижности нейтрофилов связывают многие заболевания. Поэтому изучение механизма движения представляет актуальную задачу современной медицины. На сегодняшний день накоплен достаточно большой материал, который позволяет выстраивать гипотезу относительно движения нейтрофилов. Однако эти гипотезы трудно проверить экспериментально потому, что эти методы основаны на покадровой съемке с фиксированным временным интервалом. Простое визуальное наблюдение не позволяет накопить достоверный материал, поэтому приходится прибегать к математическому моделированию.
Модель показывает, какое большое значение в оценки двигательной активности нейтрофила имеет выбор величины межкадрового интервала.
В наших экспериментах, для оценки внешнего движения (перемещение сравнимое с диаметром клетки) был выбран одноминутный межкадровый интервал, а для оценки движения, связанного с изменениями площади клетки, был выбран двухсекундный интервал.
Задачей дипломной работы было создание математической модели движения популяции клеток. Эта модель должна имитировать процесс движения клеток, процесс измерений основных характеристик движения. А полученные на модели результаты должны сравниваться с соответствующими экспериментальными данными, полученные в институте хирургии им А. В. Вишневского.
Общая характеристика
Нейтрофилы – одни из типов белых кровяных клеток – лейкоцитов.
рис. 1 Нейтрофилы
Нейтрофилы многочисленные и очень подвижные клетки. При появлении бактерий нейтрофилы начинают активный выход в ткани, где движутся в очаг воспаления с помощью различных реакций инактивируют (поглощают и разрушают бактерии).
Нейтрофилы – проявляют следующие функции:
1. Способность к адгезии (прилипание) и изменение формы.
2. Способность к движению
а) случайное блуждание;
б) хемотаксис (направленное движение отдельных клеток под влиянием односторонне действующего стимула – химического вещества)
в) хемокинез (реакция на внешний стимул, выражающиеся в изменении скорости, частоты, смены периодов движения или частоты и амплитуды поворотов во время случайного блуждания.)
3. Способность к распознаванию чужеродных агентов.
Нейтрофил с помощью рецепторов распознает бактерии.
4. Способность к фагоцитозу.
Фагоцитоз – активный захват и поглощение частиц – нейтрофилами. Фагоцитоз – одна из защитных реакций организма, главным образом при воспалении, открыт в 1883 г. И. И. Мечниковым.
5. Микробицидная активность.
Продукция кислородных радикалов и секреция ферментов, содержащихся в гранулах.
Нарушение любой из этих функций нейтрофила приводит к осложнению воспалительной реакции. (Quie P.G. Mills E.L., McPhail L.C. Johnston R.B. 1987)
Нейтрофилы созревают в костном мозге в течении 6-11 дней, после чего выходят в кровяное русло, где передвигаются током крови и дозревают около 10 часов. Зрелые нейтрофилы выходят в ткань, где движутся от 24 до 48 часов.
При инфекции кинетика этих процессов ускоряется (RepoH 1987).
Различают 3 состояния существования нейтрофилов:
1. Клетки костномозгового резерва. Такие клетки отличаются меньшей адгезивностью и хемолюминисценцией на действие активатора.
2. Клетки пассивно циркулирующие в кровяном русле.
3. Клетки прикрепленные к слою клеток, выстилающих внутреннюю поверхность кровяных и лимфатических сосудов. Выход нейтрофилов в ткань происходит через 2-4 часа после появления инфекции.
Существует 3 этапа выхода нейтрофилов в ткань:
1. Краевое стояние лейкоцитов у внутренней поверхности эндотелия сосудов воспаленной ткани.
2. Диапедез – прохождение лейкоцитов через стенку эндотелия (длится несколько минут).
3. Движение нейтрофилов в области воспаления.
Выйдя в ткань, нейтрофил начинает активное движение в области воспаления.
Рецепторы в плазматической мембране
В покоящемся состоянии нейтрофилы очень слабо проявляют свои возможности, но они могут быть активированы через мембранные рецепторы. Имеются рецепторы на определенные вещества которые выделяются в тканях в процессе воспаления. Специфические рецепторы на мембране идентифицированы для C5a белкового фрагмента комплемента, N – формил - пептида, липидного хемоаттрактанта лейкотриена B4 (Snyderman R, Goetzl E.J. 1981). Фрагмент комплемента C5a образуется в плазме крови при активации комплимента. N – формил-пептид является продуктом бактерий, и митохондрий поврежденных тканей. LTB4 - Липидный медиатор, высвобождаемый при активации различных клеток, в том числе и самих нейтрофилов. К распознаванию чужеродных для организма частиц и поглощение их есть мембранные рецепторы к C3b и C3bi факторам комплемента. При адгезии нейтрофилов к эндотелию сосудов, есть рецепторы адгезии – интегрины и селектины (Springer T.A. 1990). Взаимодействие интегринов с адгезивными белками, содержащими специфическую аминокислотную последовательность Arg – Gly – Asp (RGP – последовательность) влияет на адгезивность клеток, и участвуют в активации нейтрофилов. RGP последовательность угнетает респираторный взрыв нейтрофилов на формил – пептид и, возможно, защищает их от спонтанной активации в кровяном русле.
Механизмы активации нейтрофилов
Под активацией нейтрофилов подразумеваются быстро наступающие изменения физиологической и биохимической активности при действии внешнего сигнала. Критерием активированного состояния принято считать появление респираторного взрыва и секреторной дегрануляции (Маянский А. Н., Маянский Д. Н. 1989).
Наиболее характерным ответом нейтрофилов на присоединение агонистов к рецепторам является накопление в нейтрофилах перекиси водорода для того, чтобы убить бактерии нейтрофил нарабатывает активные радикалы кислорода, уничтожая при этом не только бактерии, но и другие клетки организма – хозяина. Респираторный взрыв подчиняется сильному контролю из – за того, что его продукты высоко реактивны и токсичны. Такой «взрыв» направлен и против организма - хозяина и приводит к повреждениям тканей. При сильных повреждениях тканей у больных, когда есть возможность хирургического вмешательства, антибактериальной терапии, врачи избегают естественного течения воспалительного процесса и применяют противовоспалительную терапию.
В зрелых нейтрофилах существует два основных типа гранул: азурофильные и специфические. При воздействии на нейтрофилы растворимыми агонистами происходит дегрануляция нейтрофилов. Часть гранул, расположенных в близи плазматической мембраны сливается с мембраной и содержимое гранул высвобождается во внеклеточную среду. С наружной клеточной мембраной сливаются сначала специфические гранулы и уже затем – азурофильные. Такой тип дегрануляции характерен для «несостоявшегося фагоцитоза». При состоявшемся фагоцитозе бактерия захватывается мембраной нейтрофила со всех сторон, попадает в цитоплазму, где происходит её разрушение.
В нейтрофилах обнаружены универсальные механизмы передачи сигналов через G- белки, систему вторичных мессенджеров и фосфорилирование с участием протеинкиназ. G – белки представляют семейство гомологичных белков, плазматической мембраны, которые переносят информацию с рецепторов на ряд мембранных ферментов. Через G – белки действуют все агонисты, регулирующие активность аденилатциклаза, фосфолипазы А2 , калиевых каналов. Фермент аденилатциклазы является интегральным белком плазматической мембраны, этот фермент отвечает за синтез сАМР в клетке. Одним из ранних событий после взаимодействия хемоаттрактантов с рецепторами является гидролиз мембранных фосфолипидов и образование биологически активных липидов. В процессе активации нейтрофилов участвуют три типа фосфолипаз: Фосфолипаза А2 (PLA2 ), фосфолипаза С(PLC), фосфолипаза D(PLD) (Thelen et al. 1993).
Активация фосфолипазы С хемоаттрактантами осуществляется через G – белки. Фосфолипаза С расщепляет фосфолипид с образованием двух вторичных мессенжиров. Инозитолтрисфосфата (IP3 ) и диацилглицерина (DAG). Инозитолтрисфосфат связывается с рецепторами на внутриклеточных запасниках кальция, локализованных вблизи плазматической мембраны. Связывание IP3 с рецепторами индуцирует высвобождение, Са++ из запасников и увеличение концентрации свободного Са++ в цитоплазме. Другой вторичный мессенжер диацилглицерин остается ассоциированным с плазматической мембраной и активирует протеинкиназу С (Omann et al. 1987, Thelen et al. 1993).
Механизм активации фосфолипазы А2 неизвестен.
Фосфолипаза D нейтрофилов Са++ зависима, она гидролизует фосфатидилхолин с образованием потенциального вторичного мессенжира – фосфатидной кислоты. Фосфатидная кислота расщипляется с образованием диацилглицерина – физиологического активатора протеинкиназы С. Процессы протекающие на плазматической мембране при взаимодействии легандов с рецепторами приводит к образованию в клетке низкомолекулярных продуктов циклических нуклеотидов, диацилглицерин, ионы кальция.
Циклические нуклеотиды не являются активаторами нейтрофилов, хотя кратковременное увеличение сАМР в нейтрофилах наблюдается при различных рецепторных активациях. Увеличение содержания сАМР угнетает двигательную активность нейтрофилов. (Галкин А.А. и соавт. 1994)
сАМР не блокирует быстрого увеличения внутриклеточного Са++ при активации нейтрофилов хемоаттрактантами. (Takenawa T., Ishitoya J., Nagai Y. 1986).
Дибутирильный сGMP сам по себе не вызывает активацию нейтрофилов и модулирует активацию нейтрофилов вызванную различными хемоаттрактантами сGMP в концентрациях в отличие от сАМР, значительно усиливает миграцию нейтрофилов (Галкин А.А. и соавт. 1994).
Ионы кальция основной частью находится в связанном состоянии и заключаются в ядре и митохондриях. При стимуляции нейтрофилов хемоаттрактантами происходит Са – зависимое кратковременное преходящее увеличение внутриклеточной концентрации Са++ , которое обеспечивается из 2х источников; быстрого высвобождения Са++ из обмениваемого внутриклеточного источника и поступления Са++ извне. Извне Са++ поступает через плазматическую мембрану, проходит через рецепторуправляемые кальциевые каналы. Поддержание равновесия концентрации Са в клетке обеспечивается с одной стороны выведением Са++ из цитоплазмы кальциевыми насосами, с другой поступлением Са++ из окружающего раствора. Участие Са++ в регуляции активности нейтрофилов не ясно. Можно сказать, что подвижность нейтрофилов либо не связана с изменениями, либо связана с небольшими локальными изменениями внутриклеточной концентрации Са++ .
Форболовые эфиры активируют нейтрофилы, вызывают дегрануляцию, респираторный взрыв, увеличение содержания F – актина без увеличения внутриклеточной концентрации Са++ .
Диоцилглицерин вызывает активацию специфического фермента клеток протеинкиназ С. Протеинкиназа С активируется на короткое время, но последствия её активации имеют длительный характер.
Подвижность нейтрофилов
Лейкоциты способны двигаться в тканях и через стенки сосудов, а также по поверхности чужеродного субстрата (стекло). При движении клетка изменяет форму.

рис. 2 Движение нейтрофила по субстрату.
Двигательный акт у ползающих клеток начинается с образования на переднем конце клетки отростка - ламеллоподии, далее в выступ, образованный прозрачной бесструктурной цитоплазмой, переливается жидкая зернистая цитоплазма тела лейкоцита. Формирование отростков представляет активный процесс, т.к. движущая сила и энергия заложены внутри самой клетки. Отростки в зависимости от среды имеют разную форму, они могут быть в виде узких длинны микровыростов, уплощенных ламеллоподий, а также в форме пузырей (Адо А.Д. Патофизиология фагоцитов 1961). Ламеллоподии образуются спонтанно на всех краях клетки, но способность передвигать клетку приобретает та ламеллоподия, которая вступила в контакт с субстратом (Stossel T.P. 1993).. Контакты могут быть как с поверхностью другой клетки, так и с не клеточной поверхностью. Ламеллоподии могут быть как разной формы, так и разных размеров. Конец отростка, коснувшись поверхности, может образовать прочный контакт. Нейтрофил во время движения образует широкую псевдоподию на переднем конце и узкие отростки на боковых поверхностях клетки.
С помощью интерференционной микроскопии различают 2 области контакта. Двигаясь, нейтрофил образует область плотного прилипания, это хвост и боковые отростки клетки, а область менее плотного прилипания образуется с телом клетки. Так как лейкоцит способен двигаться по неклеточной поверхности (стеклу), то можно наблюдать, как клетка теряет часть мембранного и цитоплазматического материала в виде следа на стекле. Это свидетельствует о плотном контакте с субстратом. Чтобы ослабить плотность контакта надо увеличить концентрацию сывороточного альбумина (King C. et. al 1980).
Натяжение отростка примыкающего к субстрату подтягивает клетку и образует новый участок для контакта с субстратом. Реакции прилипания повторяются многократно и составляют процесс распластывания клеток (Васильев Ю.М., Гельфанд И.М. 1977). Отросток, который только что начал образовываться не может прикрепиться к субстрату (стеклу) (King C.A., Preston T. M., Miller R.H. Donovan P. 1980).
Затем идет реакция стабилизации, которая приводит к разделению края клетки на активные и неактивные участки. Разделение приводит к вытягиванию клетки в переднезаднем направлении и делает её асимметричной. Следовательно, движение клетки становится возможным лишь после возникновения асимметрии. Но до сих пор неясна роль бегущей волны сокращения от переднего края к телу клетки и общего сокращения кортикального матрекса в хвосте клетки. Некоторые авторы считают, что сокращения в области хвоста участвуют в продавливании цитоплазмы из тела клетки в ламеллоподию (Coates T.P. et. al 1992).
На заднем конце движущейся клетки есть хвост и ретракционные волокна. Хвост представляет скопление на конце клетки концов ретракционных волокон. Хвост нейтрофила адгезивен к субстрату и в нем наблюдаются сокращения. Образовавшаяся ламеллоподия вступая в контакт с субстратом создает натяжение в хвосте клетки, вызывая этим его отрыв от субстрата и перемещение клетки вперед. Когда перемещение клетки осуществилось, ламеллоподия исчезает и наступает кратковременное «покоящееся состояние». Затем снова начинают образовываться новые ламеллоподии и ретракционные волокна, и всё повторяется сначала (Нерсесова 1977).
Цитоплазма у нейтрофилов находится в постоянном движении. Когда клетка пребывает в состоянии покоя, то токи цитоплазмы беспорядочны, а когда клетка движется, они направлены внутрь ламеллоподии на ведущем крае.
Нейтрофил способен производить сокращения. Это предполагает наличие сократительных структур. Актин и миозин - белки, которые находятся в мышечных клетках. В нейтрофилах, которые не имеют мышечных структур, тем не менее, есть белки сходные с актином и миозином. Актиноподобный белок очень похож на мышечный актин по молекулярному весу, структурной организации, способности активировать миозиновую АТФазу, связываться с миозином. У клеток, которые имеют не мышечную подвижность, актин вместе с миозином составляет сократительную систему, но при этом актин выступает как структурный белок. В не мышечных клетках 50% актина находится в неполимеризованной форме (G – актин), а в мышечных клетках актин на 100% полимеризован (F – актин). Такое содержание актина G и F в не мышечных клетках обусловлено взаимодействием актина с актин – связывающими белками. Известно более 100 актин связывающих белков. Альфа – актинин сшивает филаменты F – актинового геля. Другой важный белок это гельзолин. Он принимает участие в локомоции (движение обеспечивающее активное перемещение в пространстве) и транспорте везикул (пузырьков) через кортекс.
Миозиноподобные белки составляют очень малый процент (от 0.2-0.8% от общего содержания белков клетки). Молярное отношение актина к миозину в полиморфно-ядерных лейкоцитах составляет 100:1. (Crawford N., Chahal., Jackson P. 1980) Миозиноподобные белки являются ферментами, они обладают АТФазной активностью и способностью соединяться с актином. (Красовская И.Е. 1977; Omann G. M. et al 1987).
Предполагается, что в области псевдоподий актин деполимеризован. Асимметрия F – актина возникает ещё в неполяризованных клетках при активации их хемоаттрактантами и предшествует возникновению клеточной асимметрии. Снижение содержания F – актина уменьшает жесткость актинового каркаса клетки и каркас продавливается в области где произошла деполимеризация актина. Начальная реакция полимеризации актина не зависит от концентрации Ca++ в нейтрофилах, а реакция деполимеризации актина зависит от внутриклеточного Са++ . Вторая фаза полимеризации актина зависит от концентрации внутриклеточного Са++ и возможно связана с функциями нейтрофила, такими как респираторный взрыв и дегрануляция. Одновременно с полимеризацией актина при действии хемоаттрактантов происходит фосфорилирование миозина. Фосфорилирование миозина и обнаружение миозина в области псевдоподии указывает на участие сократительного аппарата в образовании псевдоподии. (Omann G.M. et. al 1987)
Методы исследования подвижности нейтрофилов
Впервые скорость движения отдельных нейтрофилов измерил McCutcheon в 1923 году.
В 1962 году Boyden разработал метод количественной оценки подвижности популяции нейтрофилов. Метод заключается в миграции лейкоцитов через тонкий фильтр, который разделял камеру на два отсека. В верхний отсек помещали суспензию клеток, клетки оседают на фильтр и переходят через поры в нижний отсек. Размер пор для нейтрофилов 3 мкм, для эозинофилов 5 мкм, для макрофагов 8 мкм. Чтобы оценить хемотаксис нейтрофилов, нужно нижний отсек заполнить раствором содержащий хемоаттрактант. Этот метод эффективен в оценке хемотаксиса, но не случайного блуждания т.к. движение лейкоцитов не является свободным. Недостаток этого метода в том, что он не позволяет наблюдать клетки в процессе движения, а оценка двигательной активности по самым подвижным клеткам популяции.
В 1975 году был изобретен новый метод исследования подвижности под агарозой. Чашки Петри заполняются горячим раствором агарозы в физиологическом растворе. При застывании раствора образуется гель, в котором проделывают лунки до дна чашки, а в лунки помещают суспензию клеток. Клетки начинают двигаться через лунки на дно чашки Петри под гель, по радиусу разбегания оценивается свободное блуждание. Если надо исследовать хемотаксис, то рядом с первой лункой делают ещё одну, в которую помещают раствор хемоаттрактанта. Агарозный гель полупрозрачен и можно наблюдать через микроскоп за живыми клетками. Недостаток метода является длительное время инкубации для получения картины разбегания клеток из лунки.
При использовании методов, описанных выше, необходимо проводить дополнительные исследования для различения случайного блуждания, хемотаксиса или хемокинеза. Такие методы исследования не дают возможности изучать отдельные клетки во время движения.
В 1953 году Харрис впервые использовал автоматический метод съемки движущихся нейтрофилов. Этот метод был использован в клинических исследованиях.
Полностью автоматизированные методы появились, когда были решены проблемы оптического выделения объектов и были созданы программы слежения за движущимися клетками (Туманов и соавт. 1990). В исследовании подвижности нейтрофилов важен выбор межкадрового интервала. В экспериментах (Hartoman R. S. el al 1994), средняя скорость движения при интервалах регистрации 4 сек. была 17 мкм/мин., а при интервалах 36 сек, составляла 9.9 мкм/мин. Отличие связано с тем, что размер нейтрофила составляет 10 мкм, а время нужное на перемещение равное клеточному диаметру приблизительно равно 1-1.5 минут. Поэтому для оценки внешнего движения используют 1 минутный межкадровый интервал, нейтрофилы за этот интервал времени перемещаются в среднем на величину клеточного диаметра. Такая регистрация позволяет оценить воздействие химических и физических факторов на подвижность нейтрофилов, проводить сравнение в норме и патологии.
Регистрация внутреннего движения используется для более подробного исследования изменений подвижности. Для этого выбирается межкадровый интервал такой, чтобы при непрерывном измерении перемещение центра массы клетки, связанное с изменением формы клетки за время межкадрового интервала не превышало клеточного диаметра (Hartman R. S. Lau K. Chou. W. Coates T. D. 1994).
Анализ траекторий случайного блуждания клеток, которые регистрируют с интервалом 2 сек. показывает, что поведение клеток отличается на малых и больших временах наблюдения. По степени корреляции разделяют два вида траектории движения:
1. Персистентное движение – клетка некоторое время пытается сохранить величину и направление движения.
2. Диффузионное движение – связано с внутренними процессами в клетке стремящимися изменить направление движения клетки.
Среднее время перехода между этими двумя формами движения называется характерным временем или временем персистентного движения (Tranquillo R.T. at al 1988).
Движение нейтрофилов изучали на покровных стеклах. Движение клеток происходит по определенной траектории, у каждой клетки она своя. Форма траекторий разнообразна, от плотного клубка до расплетенных нитей. Нейтрофилы бывают: медленные, средние и быстрые. Медленные – это клетки, которые вытягивают ламеллоподии в разные стороны, но в результате отсутствия скоординированного двигательного акта они стоят на месте или движутся но очень медленно. Средние клетки имеют траекторию более запутанную в виде плотного клубка из-за того, что они больше стоят на месте и углы поворотов у них больше. Быстрые клетки имеют меньшие углы поворотов и меньше времени стоят на месте, следовательно, их траектория более прямая. Такой вывод был сделан по произвольно выбранным клеткам. Время пребывания в фазе активности и углы поворотов определяются внутренней программой клетки.
Подвижность нейтрофилов может служить показателем тяжести состояния больных с раневой инфекцией.
Табл. 1 Средняя скорость движения и процентный состав нейтрофилов в группах здоровых доноров и больных с раневой инфекцией.
ГРУППЫ |
СКОРОСТЬ мкм/мин |
МЕДЛЕННЫЕ % |
СРЕДНИЕ% |
БЫСТРЫЕ % |
| ЗДОРОВЫЕ |
8.8 ± 0.2 |
16 |
28 |
56 |
| СР. ТЯЖЕСТИ |
6.5 ± 0.3 |
27 |
34 |
39 |
| ТЯЖЕЛЫЕ |
3.3 ± 0.3 |
58 |
27 |
15 |
У тяжелых больных средние скорости нейтрофилов распределены в диапазоне от 0 до 6 мкм/мин. Такой широкий диапазон средних скоростей из-за того, что больные подвергаются интенсивному лечению (операции, антибиотикотерапия). У больных средней тяжести, скорости распределены в области от 4.5-9 мкм/мин. Ухудшение состояния больного происходит из-за уменьшения клеток в популяции. При тяжелом состоянии средняя скорость в популяции ниже 3 мкм/мин, а скорость 5-6 мкм/сек говорит о том, что состояние средней тяжести.
Нарушение подвижности нейтрофилов было обнаружено у ожоговых больных и больных с острой пищевой токсикоинфекцией. В каждой группе было исследовано по 5 больных. В группу ожоговых больных входили тяжелые больные с площадью ожогов 50% поверхности тела. Группу с острой пищевой токсикоинфекцией составляли больные с тяжелой сальмонеллезной эндотоксимией. У этих больных интоксикация приводит к сильному угнетению подвижности нейтрофилов.
Табл. 2 Скорость движения и процентный состав неподвижных, медленных и быстрых нейтрофилов у ожоговых больных и больных с острой пищевой токсикоинфекцией.
| Больные |
Ожоги |
Пищевая токсикоинфекция |
| N = 5 |
Скор. % состав мкм/мин м:с:б |
Скор. % состав мкм/мин м:с:б |
| СРЕДНИЕ |
3.2 62:24:14 |
2.1 75:19:6 |
| ОШ. СРЕДНЯЯ |
0.4 |
0.5 |
Бактерии способны выделять хемоаттрактанты, которые притягивают нейтрофилы в зону инвазии (способность возбудителей проникать и распространяться в организме). Бактериальные хемоаттрактанты типа формил – пептида при больших концентрациях проявляют эффект «западни» угнетая движение нейтрофилов.
В поле зрения микроскопа клетка движется по случайной траектории. Из начального положения клетка может перемещаться на случайное расстояние в отрезке от 0 до rmax , под случайным углом от 0 до ±1800 .
Случайный шаг характеризуется распределением:
рис. 3 Распределение (частота встречаемости) шагов, на которые клетка перемещается за выбранный промежуток времени (1 минута).
Клетка во время движения может менять как шаги, так и углы поворотов, от 0 до 1800 . Углы меняются по отношению к предыдущему направлению клетки.
Случайные углы поворота нейтрофилов характеризуются распределением:
рис. 4 Распределение углов поворотов при случайном движении. Углы распределены от 0 до 1800, знак угла считается равновероятным.
Из распределения углов поворота видно, что нулевой угол встречается чаще, следовательно, он наиболее вероятен, а угол 1800 наименее вероятен. Из этого следует, что клетка при движении сохраняет свое направление. Углы поворотов распределены от 0 до 1800 , при этом знак угла считается равновероятным (вправо или влево). В соответствии с такой гипотезой строится алгоритм модели движения клетки.
Нейтрофилы разделены на три типа: быстрые, средние и медленные. Три типа клеток различаются между собой по максимально возможному шагу в единичном акте движения. Для медленных клеток эта величина составляет 3 мкм (величина меньше размера клетки). Для средних клеток – 10 мкм (величина, немного превышающая размер клетки). Для быстрых клеток составляет 30 мкм.
Вычисление координат клетки
Координаты каждой последующей клетки вычисляются из предыдущего. Программа генерирует три случайных числа в соответствии с заданными распределениями (для каждого вида нейтрофилов своё распределение)
ri - случайный шаг.
ji - угол поворота.
signi - направление поворота.
Вычисляем угол по отношению к оси 0X.
F i = F i-1 + signi ´ j i
xi = xi-1 + ri cos F i
yi = yi-1 + ri sin F i
рис. 5 Движение нейтрофила по случайной траектории.
Во время работы модели вычисляется на каждом шаге пройденный клеткой путь и строится график зависимости пройденного пути от времени.
Генерация случайных чисел с заданным распределением (Монте-Карло)
Пусть величина y принимает значения y1 ,y2 ,…,yn , с вероятностями p1 ,p2 ,…,pn . Сумма вероятностей p1 +p2 +…+pn =1 . Разобьем отрезок [0,1] на отрезки p1 ,p2 ,…,pn .
Алгоритмические языки программирования имеют генератор равномерно распределенных псевдослучайных чисел. Если псевдослучайное число x i , равномерно распределенное на отрезке [0,1] мы будем «бросать» на отрезок, то он будет попадать в интервалы p1 ,p2 ,…,pn , с частотой, пропорциональной длине этих интервалов. Из этого следует, что числа y1 ,y2 ,…,yn будут появляться в соответствии с вероятностями p1 ,p2 ,…,pn .
Язык Pascal генерирует целые положительные псевдослучайные числа, распределённые в заданном интервале x:=random(100) . Такая процедура будет генерировать числа, равномерно распределенные в интервале [0,100].
В данной программе вероятность измерялась в процентах. Все вероятности измерялись в целых числах, что превышало точность измерений. Таким образом были построены генераторы случайных шагов, углов поворота, случайных изменений площади, случайных коэффициентов адгезии (прилипания). Единственное исключение составляло явление поворота. Если генерируемая величина была меньше 50, угол поворота положителен, и если величина больше, либо равняется 50, то угол поворота отрицателен. Для каждой вычисляемой величины, генерировалась отдельная случайная величина y , поскольку величины ri ji считаются независимыми.
Алгоритм реализации конкретного распределения. На рис. 5 показана гистограмма (дифференциальное распределение) частоты встречаемости шагов клетки за выбранный интервал (интервал времени между измерениями).

рис. 6 Дифференциальное распределение.
Всё время работы алгоритма подсчитывается частота встречаемости каждого шага по всей популяции, за все время конкретного расчета (120 шагов по 1ой минуте). Полученные результаты выводились в виде гистограмм минутных сдвигов. При построении гистограмм, все теоретические клетки «смешивались в кучу», хотя в программе заведомо заданно, что клетки относятся к разным типам.
Исходя из дифференциального распределения, строим другую гистограмму.
рис. 7 Куммулятивная гистограмма.
Полученная гистограмма называется куммулятивной гистограммой (интегральное распределение). Генерируемая процедура паскаля равномерно распределенное случайное число y обязательно попадает в один из интервалов от p1 до p5 . При его попадании в интервал pi , выбираем шаг ri , который и будет использоваться в вычислении следующего положения клетки. Очевидно, что при длительной работе алгоритма, доля шагов ri будет пропорциональна вероятности pi . Аналогичным образом вычисляется на каждом шаге все остальные параметры движения клеток.
Программная реализация алгоритма
В программе для случайной величины предусмотрена следующая таблица:
Табл. 3
| № |
Значение шага |
Частота наблюдений |
Частота в % |
Куммулятивная гистограмма |
| 1 |
R1 |
N1 |
Cent 1 |
Cent 1 |
| 2 |
R2 |
N2 |
Cent 2 |
Cent 1 + Cent 2 |
| : |
: |
: |
: |
: |
| 10 |
R10 |
N10 |
Cent 10 |
å Cent |
Величины шагов, углы площади разбиты равномерно от 0 до максимального значения. Значение, больше максимального в эксперименте не встречается. Значения частоты наблюдений обозначают частоту встречаемости этих шагов в произвольном измерении. В принципе, сумма частот встречаемости должна составлять 1 или 100%. Однако при реальном моделировании, поле приходится описывать в виде приблизительного распределения. При этом мы можем увеличивать или уменьшать частоты появления отдельных шагов. Если при этом заботиться о том, что суммы всех частот должна составлять 100%, то это сильно затруднит просмотр всех вариантов. После подгонки формы приблизительного распределения, программа нормализует сумму частот к 100% по формуле
Таким образом формируется 3-й столбец таблицы. После формирования 3-го столбца таблицы, программа формирует 4-й столбец, представляющий собой куммулятивное распределение.
В программе полученное равномерно распределенное число y последовательно начиная с 1-го сравнивается с числами четвертого столбца. При этом номер числа последовательно наращивается. Как только y превысит очевидное число из 4-го столбца, процедура заканчивает свою работу. Номер последнего числа считается номером избранного числа, значение которого извлекается из первого столбца.

рис. 8 Алгоритм генерации случайного числа, заданным распределением.
Этому алгоритму соответствует следующая процедура:
Процедура редактирования распределений
Любая программа подразумевает обеспечение «экранного сервиса». На экране должны возникать таблицы исходных данных, которые удобно редактировать. Для этого должно быть предусмотрено создание в программе текстового файла, в котором изображается экранная таблица со специальными символами. Символы обозначают будущие места, в которых будут стоять исходные данные. Заранее оговариваются специальные символы.
рис. 9 Распределение служебных мест на экране для редактирования параметров измерения.
Специальные символы, которые указывают местоположение будущих значений.
| @ |
- место переключения фона. |
| # |
- место, где будет выведено значение параметров. |
| ~ |
- место, где будут выводиться частоты. |
| ! |
- место, где строятся столбцы гистограммы. |
| * |
- либо шаг, либо угол. Название параметра. |
| $ |
- место, в которое выводится тип клетки. (slow, medium, fast). |
|
|
Процедура формирования экрана работает следующим образом. Текстовый файл считывает символ за символом. Если считанный символ не входит в список специальных, он просто выводится на экран. Таким образом, на экран могут выводиться любые комментарии, например: инструкции по редактированию таблицы. При выводе всех символов, подсчитывается номер строки и номер позиции в строке. Номер позиции в строке задаётся в начале, равный единице. И наращивается с введением каждого нового символа до появления символа eoln (end of line - конец строки). После увеличивается на единицу счетчик номера строк и сбрасывается в единицу счетчик номера позиции. Работа процедуры заканчивается eof (end of file - конец файла).
Измерение среднеквадратичного отклонения
На рис.10 показана траектория клетки.

рис. 10 Траектория движения клетки.
Вычисляются квадраты расстояния gik , т. е. между i-тым и k-тым положениями клетки. Для каждой заданной разници n = k – i усредняются вдоль траектории все квадраты gik .
При исследовании движения популяции клеток было обнаружено, что нейтрофилы, выделенные из одной и той же пробы, движутся с различными скоростями. Этот факт может объясняться многими причинами, главные из которых, по видимому, является возраст клеток, но мы не будем подробно изучать зависимость клеток от возраста.
Экспериментатор, условно разделил клетки на медленные, средние и быстрые. Количество таких клеток в популяции составляет 15 : 30 : 55. При моделировании популяции мы исходим из этого соотношения.
Программа генерировала случайное количество быстрых, средних и медленных «клеток», в среднем дающих экспериментальное соотношение. При моделировании клеток в популяции, экспериментальный шаг (шаг за единицу времени) случаен. Распределение этих шагов, задается распределением, показанным на рис. 11 .

рис. 11 Распределение элементарных шагов за единицу времени (1 минута).
Описание распределения было выбрано произвольно, так, чтобы оно напоминало экспериментальное распределение. Полный интервал возможных случайных шагов от 0 до rmax для каждого типа клеток (медленные, средние, быстрые) разбивался на 10 шагов. Зависимость частоты встречаемости каждого шага ri от величины шага гистограммы описывается формулой:
N( j ) =100 · sin ( p · j/10)
j £ 10
Таким образом, распределение элементарных шагов для всех типов клеток предполагается одинаковым. Отличается только величина возможного шага для данного типа клеток. Максимально возможный шаг составляет:
Для медленных — 3 мкм.
Для средних — 10 мкм.
Для быстрых — 30 мкм.
Распределение углов поворотов на каждом шаге для всех типов так же предполагается одинаковым.
Диапазон углов от 0 до 1800 разбивался на 10 интервалов. Таким образом, каждый шаг гистограммы соответствовал углу в 180 .
Измерение пройденного пути
Наиболее естественный показатель движения клетки в эксперименте, считается пройденный путь. На рис. 12 можно наблюдать нарастание пройденного пути в зависимости от времени.

рис. 12 Зависимость пройденного пути от времени. Три группы клеток (max_step: 3, 10, 30 mcm - соотношение 15:30:55)
Показано движение 15 клеток из 30, которые генерировала модель. Наиболее удивительным в эксперименте был факт постоянной скорости движения клеток в течении всего эксперимента, не смотря на случайный характер их движения. Модель хорошо воспроизводит этот факт, при этом случайные колебания скорости практически незаметны. Каждая отдельная кривая представленная на рис. 12 хорошо соответствует экспериментальным данным рис. 13 . Однако из сравнения рис. 12 и рис. 13 видно, что в эксперименте существуют все варианты скоростей движения, а в модельном эксперименте, четко выделяются три группы клеток.

рис. 13 Зависимость пройденного пути от времени (эксперимент)

рис. 14 Зависимость пройденного пути от времени. Три группы клеток (max_step: 3, 10, 30 mcm соотношение 1:1:1)
Таким образом, условное деление клеток на группы, введенное экспериментатором не может быть основой для моделирования. При изменении процентного состава клеток в популяции рис. 14 видно, что характер распределения клеток по скоростям не изменяется. В обоих случаях четко выделяются три группы клеток, которые и были заложены в модель.
При моделировании популяции был проведен еще один эксперимент рис. 15 , все параметры движения были такими, как и в предыдущем эксперименте.

рис. 15 Зависимость пройденного пути от времени. Три группы клеток (max_step: 3, 10, 30 mcm, соотношение 1:1:1 время измерения каждый десятый шаг)
Однако «теоретический наблюдатель» имел возможность регистрировать положение клеток только на каждом 10-м шаге. В этом случае существование трех групп клеток практически не видно. Это связано с тем, что траектория движения клеток запутанная. Часто встречаются случае, когда клетки за 10 шагов успевают повернуть на зад. Таким образом, на каких-то участках траектории «возникает иллюзия» малых шагов у быстрых клеток и возникает картина, похожая на экспериментальную. Интересно отметить, что максимальная скорость измерения упала в 3 раза (приблизительно Ö10) по сравнению с заданной в программе. Последний расчет указывает на то, что выбор интервала времени, для последовательного положения клеток, очень существенен.
В экспериментах положение клетки оценивалось как положение её центра масс. Ясно, что координаты меняются от изменения формы клеток. Из этого следует, что чем меньше интервал времени, между измерениями, тем точнее измерение скорости. Однако смещение центра масс на расстояние меньше размера клеток нельзя считать устойчивым. В результате, для измерения скорости был выбран интервал 1 минута, который примерно соответствует смещению средних клеток на расстояние порядка их размера.
Последний рисунок не смотря с его схожестью с экспериментом не может считаться истинным. Таким образом приходим к выводу, что деление сделанное экспериментатором на быстрые, средние и медленные клетки очень условно и его можно принимать только как некую мнемонику.
Таким образом, было введено принципиальное изменение в модели рис. 1 6 . В популяции присутствовали клетки с непрерывно распределенными скоростями, а не три ярко выраженные группы. Распределение минутных сдвигов для каждой клетки было принципиально таким же, как и в предыдущей модели. Сдвиги распределены от 0 до rmax , а величины rmax в популяции были распределены в соответствии с таким же распределением. Генерировалась случайная популяция клеток, после чего для каждой клетки генерировались сдвиги, и рассчитывалось движение клеток в популяции. Результат расчета, показанный на рис. 1 6 , полностью совпадает с экспериментальным. Мы моделировали не только перемещение, но и процесс измерения перемещений. Процедура измерений перемещений просматривала все движущиеся клетки, не зная к какой группе относится каждая из них.

рис. 16 Зависимость пройденного пути от времени. Клетки распределены непрерывно (max_step: 30 mcm, соотношение случайное, время измерения каждый шаг)
В результате она смешивала все клетки и строила гистограмму
рис. 1
7 – 1
9
. Все полученные гистограммы не имели характерных особенностей и были, в принципе, похожи друг на друга. В результате приходим к важному выводу – измерение гистограмм, в эксперименте, не дает существенной информации о характере движения. Такой же вывод будет сделан и в параллельной работе при более детальном анализе каждой отдельной клетки.

рис. 17 Гистограмма минутных сдвигов. Три группы клеток (max_step 3, 10, 30 соотношение клеток 15:30:55)
рис. 18 Гистограмма минутных сдвигов. Три группы клеток (max_step 3, 10, 30 соотношение клеток 1:1:1)

рис. 19 Гистограмма минутных сдвигов. Три группы клеток (max_step 3, 10, 30 соотношение клеток 1:1:1, время измерения каждый десятый шаг)
Исследование зависимости среднеквадратичного отклонения от времени наблюдения
Как известно из теории Броуновского движения, важным показателем случайного блуждания является среднеквадратичное отклонение. Мы использовали этот показатель для движения нейтрофилов. Прежде всего, мы рассматривали частицу, у которой углы поворотов распределены равномерно, т.е. клетка с равной вероятностью может повернуть в любую сторону. Результат показан на рис. 20 .

рис. 20 Расномерное распределение углов.
На этом рисунке по оси ординат отложен ln времени. По оси абсцисс отложен ln среднеквадратичного отклонения клетки. Как показано Энштейном и Смолуховским для броуновской частицы, эта зависимость отображается прямой с наклоном 0,5. Как видно, наша кривая хорошо ложится на прямую с наклоном 0,5. Для сравнения, на этом же графике проведена прямая с наклоном 1. Если бы клетка не поворачивалась вообще, то её среднеквадратичное отклонение легло бы на прямую с наклоном 1. Результат показан на рис. 21 .

рис. 21 Почти нулевой угол поворотов.
Здесь на всякий случай оставили небольшую вероятность (2%) поворота на 180 . В результате среднеквадратичное отклонение этих клеток слегка отклоняется от прямой.
При задании в модели экспериментально измеренных распределений углов поворотов рис. 22 получили кривые поразительно похожие на эксперимент. В начале, среднеквадратичное отклонение идет вдоль прямой с наклоном 1, затем отклоняется и асимптотически стремиться к наклону 0,5 рис. 23 – 24 . Такой характер зависимости в литературе принято трактовать как клеточную память. В нашей модели процесс был принципиально марковским. В каждый момент времени распределение углов и сдвигов не зависело от предыстории. И тем не менее картина воспроизводилась с точностью до времен. Конечно если трактовать память в бытовом смысле, то элементы памяти в модели есть. Все-таки нулевой угол поворота по отношению к предыдущему шагу является предпочтительным.

рис. 22 Гистограммы углов заданных поворотов.
рис. 23 Обычное распределение углов fast.

рис. 24 Обычное распределение углов slow.

рис. 25 Гистограмма углов заданных поворотов (хемотаксис)
Однако памяти, в математическом смысле, в модели нет.
Если мы сделаем нулевой угол еще более предпочтительным рис. 25 , то естественно получим кривую среднеквадратичного отклонения, очень близкую к кривой, получаемой при хемотаксисе.
Очень важный результат, для нашей экспериментальной группы, можно видеть на рис. 23 . Кривая среднеквадратичного отклонения на больших временах начинает снижаться с отрицательным наклоном. Естественно, что для броуновской частицы это невозможно. Из модели ясно, что это отклонение связано с недостатком статистики для вычисления последних точек. На рис. 26 приведены графики многих клеток.

рис. 26 Зависимость среднеквадратичного отклонения. Клетки распределены непрерывно (max_step: 30 mcm соотношение случайное время измерения каждый шаг)
Видно, что в каких-то клетках это явление наблюдается или не наблюдается вообще или загибается «хвостик» вверх. Загибание «хвоста» вниз в эксперименте может означать только одно, клетка закономерно стала возвращаться к исходной точке. В результате стало возникать подозрение, что на экспериментальных стеклышках имеются какие-то условия (например царапины), которые обеспечивают не случайное движение. Такое подозрение ставит под сомнение и все другие результаты.
На модели нам удалось показать, что это, скорее всего, только недостаток статистики для вычисления последних точек. И их не нужно принимать во внимание.
В последние годы в литературе наметился быстрый рост количества работ, посвященных движению клеток крови – нейтрофилов. Это связанно с двумя основными факторами: появление новых современных методов изучения движения и бурным нарастанием знаний о внутриклеточной регуляции жизненно важных процессов.
Установлено, что на сегодняшний день объем знаний в медицине нарастает в полтора – два раза быстрее, чем в любой другой науке. Новые методы изучения движения клеток связаны в первую очередь с развитием систем анализа изображения. Ясно, что эти методы имеют большое преимущество над традиционными, которые опирались на изучение «диффузии» популяции. Методы анализа изображения позволяют изучать не только миграцию клеток, но и изменение их формы, связанное с вытягиванием псевдоподии. В настоящее время накоплен очень большой материал по формальному описанию движения клеток, развита теория описания движения, основанная на анализе случайных процессов. Однако многие вопросы остаются до сих пор непонятными. Отчасти это связанно с недостатком знаний и не возможностью провести прямые измерения параметров ряда процессов, определяющих движение клетки. Например, из экспериментальных данных ясно, что движение клеток связано с их прилипанием к стеклу, по которому они движутся. Если клетка не прилипает к стеклу вообще, то она не движется. Если же она прилипает очень сильно, то она опять не в состоянии двигаться. До сих пор не существует методов измерения степени прилипания клетки к стеклу. Разумеется в распоряжении исследователя даже нет средств для измерения многих физических характеристик движения, но он имеет множество возможностей изменять эти характеристики. В этих условиях, важным шагом, который может обеспечить дальнейшие исследования, является математическое моделирование. Математическое моделирование позволяет исследователю упорядочить и систематизировать имеющиеся знания. Проверить непротиворечивость выдвинутых гипотез и выделить существенные и не существенные факторы высказываемых в них.
Модель движения популяции нейтрофилов не учитывала изменение формы отдельных клеток, а ограничивалась результирующими параметрами каждой клетки. Клетка могла переместиться в случайном направлении (распределение углов поворотов задавалось на случайное расстояние), на случайное расстояние (распределение также задавалось). Популяция была разбита на 3 группы: медленные, средние и быстрые. Это распределение было взято из экспериментальной практики, при этом модель учитывала даже процентное соотношение в популяции. В результате моделирования установлено, что первая из зависимостей (зависимость пройденного пути от времени) совершенно не соответствует экспериментальной. Положение не спасало и изменение процентного состава клеток в популяции. Единственный выход, подсказанный моделью, это отказ от деления популяции на группы и введение непрерывно распределенных скоростей.
Моделирование выбора интервала времени для измерений последовательных положений клеток, для измерения скоростей, показало, что не только значения мгновенных скоростей зависит от интервала, что само по себе очевидно. Выбор слишком большого интервала «размазывает» популяционные характеристики движения, приближая модельную картину к экспериментальной. Это очень опасный артифакт. Как и обсуждается в главе результаты исследований, временной интервал для измерения мгновенных скоростей должен быть порядка времени перемещения клетки на расстояние сравнимое с её размером. При этом показано, что даже при «правильном измерении» построение гистограмм элементарных перемещений практически не несет никакой информации ни о характере движения клеток, ни о популяционном составе. Изучение классического параметра случайного движения – среднеквадратического отклонения показало, что на малых временах клетки ведут себя как объекты, движущиеся целенаправленно. На больших временах клетки ведут себя как броуновские частицы.
Применение веществ, которые привлекают клетку к себе (хемоаттрактанты) увеличивают интервал времени, в течении которого клетка движется целенаправленно. Само по себе это не удивительно. Однако в литературе широко принято связывать это явление с клеточной памятью. Наша модель была в принципе марковской. В ней небыло памяти в строгом смысле слова. В не строго смысле некий элемент, который можно трактовать как память был. Нулевой угол поворота был более предпочтителен, а при применении хемоаттрактанта вероятность нулевого угла увеличивалась. Тем не менее модель воспроизводила экспериментальные данные с поразительной точностью. Воспроизводилось даже время с целенаправленным движением. Таким образом попытки интерпретации этого времени как клеточной памяти вызывают серьезные сомнения. Очень важными оказались результаты моделирования среднеквадратичного отклонения на больших временах. График зависимости среднеквадратичного отклонения от времени начинает отклоняться от теоретического в случайном направлении, в плоть до того, что среднеквадратичное отклонение начинает уменьшаться. Эта особенность, полученная в эксперименте, «вызвало панику» у экспериментаторов. Уменьшение среднеквадратичного отклонения можно было интерпретировать только как целенаправленное возвращение клетки обратно. Физически это можно представить себе как возвращение клетки вдоль некоторого дефекта подложки, невидимого в микроскоп. Разумеется, это ставит под сомнение качество всего эксперимента. На модели показано, что это явление связано всего лишь с недостатком статистики для последнего участка кривой.
Выводы
1. Создана популяционная математическая модель случайного блуждания нейтрофилов, которая описывает основные характеристики движения;
2. Широко принятое в литературе деление нейтрофилов на медленные, средние и быстрые следует считать условным. Экспериментальные измерения скоростей нейтрофилов в популяции распределены непрерывно;
3. Модель подвергает сомнению широко принятое мнение о существовании памяти нейтрофилов. Экспериментальные данные хорошо описываются в рамках марковской модели;
4. Наблюдаемое в эксперименте закономерное возвращение некоторых нейтрофилов к начальной точке связано только с недостатком статистики для измерения среднеквадратичного отклонения на больших временах.
1. Boyden S. The chemotactic effect of mixtures of antibody and antigen on polymorphonuclear leukocytes. J. Exp.Med., 1962, v.115, 453-465.
2. Coates T.D. et al. Relationship of F-actin distribution to development of polar shape in human polymorphonuclear neutrophils. J.Cell Biol. 1992, v.117, N4, 765-774.
3. Crawford N., Chahal H., Jackson P. The isolation and characterisation of guineapig polymorphonuclear leucocyte actin and myosin. Biochim. et diophis acta, 1980, v.626, N1, 218-233.
4. Harris H. Chemotaxis of granulocytes. J. Pathol. Bacteriol., 1953, v.66, 135-140.
5. Hartman R.S., Lau K. The fundamental motor of the human neutrophil is not random: Evidence for local non-Markov movement in neutrophils. Biophys. J., 1994, v.67, 2535-2545.
6. King C.A. et al. Cell-substrate interactions during amoeboid locomotion of neutrophyl leukocytes., Exp. Cell Res., 1980, v.126, 453-458.
7. Nelson R.D., Quie P.G. Chemotaxis under agarose: a new and simple method for measuring chemotaxis and spontaneous migration of human polymorphonuclear leukocytes and monocytes. J. Immunol., 1975, v.115, 1650-1656.
8. Omann G.M. et al. Signal transduction and cytoskeletal activation in the neutrophil. Physiol. Rev, 1987, v.67, N1, 285-319.
9. Quie P. G., Mills E. L., McPhail L. C., Johnston R. B. Phagocytic Defects Springer Semin. Immunopathol 1978, v. 1, 323-337.
10. Repo H. Defects in fagocytic functions. Annals of Clinical
11. Research. 1987, v.19, 263-279.
12. Senda N., Tamura H., Shibata N. The mechanism of the movement of leucocytes. Exp. Cell Res., 1975, v.91, N2, 393-407.
13. Snyderman R., Goetzl E. J. Molecular and cellular mechnisms of leukocyte chemotaxis. Scince 1981, v.213, 830-837.
14. Springer T. A. Adhesion receptors of the immune system. Nature, 1990, v 346, 425-434.
15. Stossel T.P. On the crawling of animal cells. Science 1993, v.260, 1086-1094.
16. Адо А.Д. Патофизиология фагоцитов. 1961.
17. Васильев Ю.М., Гельфанд И.М. Движение и морфогенетические реакции тканевых клеток в культуре. В сб. Движ.нем.кл.1977г.
18. Галкин А.А. и соавт. 1994
19. Красовская И.Е. Сократительные белки немышечных клеток . I. Актино- и миозиноподобные белки. в сб. Движение немышечных клеток и их компонентов. 1977г.
20. Маянский А.Н., Маянский Д.Н. 1989г.
21. Нерсесова Л.С. Движение немышечных клеток и их компонентов., Ленинград, «Наука» 1977г.
22. Туманов Е.А. и соавт. Бюлл. Эксп. Биол. Мед. 1990, N6, 594-597.
Текст программы математического моделирования случайного блуждания популяции нейтровилов
program neutro;
uses dos, crt, graph;
const
uparrow = #72;
leftarrow = #75;
rightarrow = #77;
downarrow = #80;
type
gr_descriptor = record
x_0,y_0 : word;
X_len,y_len : word;
X_scale, Y_scale : real;
end;
prob_mov = record
max_step : real;
cell_name : string;
step, manual : array[0..10] of real;
cent, cummulate : array[0..10] of word;
end;
scr_mod = (name_edit, arg_edit, fun_edit, diag_edit);
cell_typ = (slow, mean, fast);
par_typ = (g_shift, l_shift, angle);
scr_adr=record
x : integer;
y : integer;
end;
cell_descriptor = record
speed : cell_typ;
x, y, angle : array[1..100] of real;
end;
var
cell : array[1..30] of cell_descriptor;
step_distri : array[g_shift..angle] of prob_mov;
max_shift : array[1..30] of real;
start_x, start_y, counter : integer;
graph_scale : gr_descriptor;
key : char;
N_line, N_pix_inline : integer;
graph_X, graph_Y : array[slow..fast] of integer;
marker_place : array[arg_edit..diag_edit, 1..11] of scr_adr;
name_place, cell_place : scr_adr;
step_len, step_ang, current_x, current_y, current_a : real;
choose_cell : cell_typ;
sign : integer;
procedure draw_axis;
var
i, j : word;
bintext : string;
begin
with graph_scale do
begin
x_0:=round(N_pix_inline/40);
y_0:=round(N_line/40);
X_len:=round(N_pix_InLine-2*x_0);
Y_len:=round(N_line-2*y_0);
setlinestyle(0,0,1);
rectangle(x_0,Y_0,x_0+X_len,Y_0+Y_len);
end;
end;
procedure opengraph;
var
grdriver, grmode : integer;
begin
detectgraph(grdriver,grmode);
initgraph(grdriver,grmode,'');
N_line:=getmaxY;
N_pix_inline:=getmaxX;
start_x:=n_pix_inline div 2;
start_y:=n_line div 2;
SetBkColor(Black);
SetColor(LightRed);
cleardevice;
draw_axis;
end;
procedure readscreen(fname : string; Tcl,Tbg : word);
var
x, y, j, txt_b, txt_c : word;
i : array [arg_edit..diag_edit] of word;
a : char;
d : text;
begin
assign(d,fname);
reset(d);
txt_b:=Black;
TextBackground(txt_b);
clrscr;
y:=0;
i[arg_edit]:=0; i[fun_edit]:=0; i[diag_edit]:=0;
repeat
y:=y+1; x:=0;
repeat
x:=x+1;
read(d,a);
case a of
'.' : begin
if txt_b=Black then txt_b:=Tbg else txt_b:=Black;
txt_c:=Tcl;
textbackground(txt_b);
textcolor(txt_c);
WRITE(' ');
end;
'*' : begin
name_place.x:=x;
name_place.y:=y;
write(' ');
end;
'$' : begin
cell_place.x:=x;
cell_place.y:=y;
write(' ');
end;
'#' : begin
write(' ');
i[arg_edit]:=i[arg_edit]+1;
marker_place[arg_edit,i[arg_edit]].x:=x;
marker_place[arg_edit,i[arg_edit]].y:=y;
end;
'~' : begin
write(' ');
i[fun_edit]:=i[fun_edit]+1;
marker_place[fun_edit,i[fun_edit]].x:=x;
marker_place[fun_edit,i[fun_edit]].y:=y;
end;
'!' : begin
write(' ');
i[diag_edit]:=i[diag_edit]+1;
marker_place[diag_edit,i[diag_edit]].x:=x;
marker_place[diag_edit,i[diag_edit]].y:=y;
end;
else
write(a);
end;
until eoln(d);
readln(d); writeln;
until eof(d);
close(d);
end;
procedure readreal(var value : real; a : char; len : word; ad : scr_adr);
var LI : array[1..10] of char;
x,y,old : integer;
st : string;
begin
write(' ':len);
gotoXY(ad.x,ad.y);
LI[1]:=a; write(a); y:=2;
if a<>#13 then
repeat
a:=readkey;
if a=',' then a:='.';
if ((a='O') or (a='o')) then a:='0';
if ((a>='0') and (a<='9')) or (a='.')
then begin LI[y]:=a; write(a); y:=y+1 end;
if a=#8 then
begin y:=y-1;
gotoXY(ad.x+y-1,ad.y);
write(' ');
gotoXY(ad.x+y-1,ad.y);
end;
until a=#13;
st:=LI[1];
for x:=2 to y-1 do st:=concat(st,LI[x]);
val(st,value,old);
end;
procedure setmarker(m : scr_mod; i : integer);
begin
gotoxy(marker_place[m,i].x,marker_place[m,i].y);
end;
procedure wri_val(x : real; i : integer; old : boolean);
begin
if old
then begin textbackground(Black);
textcolor(LightGray)
end
else begin textbackground(LightGray);
textcolor(Black)
end;
setmarker(fun_edit,i+1);
write(' ':4);
setmarker(fun_edit,i+1);
write(x:4:1);
setmarker(fun_edit,i+1);
end;
procedure edit_prob(index : par_typ);
var
st : real;
j : integer;
a : char;
begin
with step_distri[index] do
begin
readscreen('distrib.scr',LightGray,Red);
gotoXY(name_place.x,name_place.y);
case index of
g_shift : write('Глобальный шаг');
l_shift : write('Локальный шаг');
angle : write('Угол');
end;
st:=max_step/10;
for j:=0 to 10 do
begin
step[j]:=j*st;
gotoXY(marker_place[arg_edit,j+1].x,marker_place[arg_edit,j+1].y);
write(step[j]:4:1);
gotoXY(marker_place[fun_edit,j+1].x,marker_place[fun_edit,j+1].y);
write(manual[j]:4:1);
end;
j:=0;
repeat
setmarker(fun_edit,j+1);
wri_val(manual[j],j,false);
setmarker(fun_edit,j+1);
a:=readkey;
if a=#0 then
begin
a:=readkey;
wri_val(manual[j],j,true);
case a of
rightarrow, downarrow : j:=j+1;
leftarrow, uparrow : j:=j-1;
end;
if j>10 then j:=10;
if j<0 then j:=0;
end;
if ((a>='0') and (a<='9')) or (a='-')
then
begin
readreal(st,a,4,marker_place[fun_edit,j+1]);
manual[j]:=st;
end;
until ((a=chr(27)) or (a=' '));
end;
end;
procedure normalize;
var
j : word;
s : par_typ;
x : real;
begin
for s:=g_shift to angle do
begin
x:=0;
for j:=0 to 10 do x:=x+step_distri[s].manual[j];
for j:=0 to 10 do
begin
step_distri[s].cent[j]:=round(100*step_distri[s].manual[j]/x);
end;
step_distri[s].cummulate[0]:=step_distri[s].cent[0];
for j:=1 to 10 do
begin step_distri[s].cummulate[j]:=
step_distri[s].cummulate[j-1]+
step_distri[s].cent[j];
end;
end;
end;
procedure make_population;
var
i, j, x : word;
begin
clrscr;
for i:=1 to 30 do
begin
x:=random(100);
j:=0;
while x>step_distri[g_shift].cummulate[j] do j:=j+1;
step_len:=step_distri[g_shift].step[j];
max_shift[i]:=step_len;
cell[i].x[1]:=500+random(1000);
cell[i].y[1]:=500+random(1000);
cell[i].angle[1]:=random(180);
if random(100)<50 then cell[i].angle[1]:=-cell[i].angle[1];
if max_shift[i]>=15 then cell[i].speed:=fast;
if (max_shift[i]>=7) and (max_shift[i]<15) then cell[i].speed:=mean;
if max_shift[i]<=7 then cell[i].speed:=slow;
end;
end;
procedure init;
var
j : word;
s : par_typ;
x : real;
c : cell_typ;
begin
step_distri[g_shift].max_step:=30;
step_distri[g_shift].cell_name:='Глобальный';
step_distri[l_shift].max_step:=30;
step_distri[l_shift].cell_name:='Локальный';
step_distri[angle].max_step:=180;
step_distri[angle].cell_name:='Углы';
s:=g_shift;
for j:=0 to 10 do step_distri[s].manual[j]:=100*sin(pi*j/10)*sin(pi*j/10);
s:=l_shift;
for j:=0 to 10 do step_distri[s].manual[j]:=100*sin(pi*j/10)*sin(pi*j/10);
s:=angle;
for j:=0 to 10 do step_distri[s].manual[j]:=100*exp(-j/2);
edit_prob(g_shift);
edit_prob(l_shift);
edit_prob(angle);
clrscr;
normalize;
make_population;
end;
procedure calc_step(i : word);
var
x, j : word;
begin
x:=random(100);
j:=0;
while x>step_distri[l_shift].cummulate[j] do j:=j+1;
step_len:=step_distri[l_shift].step[j]*max_shift[i]/30;
x:=random(100);
j:=0;
while x>step_distri[angle].cummulate[j] do j:=j+1;
step_ang:=step_distri[angle].step[j];
x:=random(100);
if x>50 then sign:=-1 else sign:=1;
end;
procedure make_all_steps;
var i, j : word;
begin
for i:=1 to 30 do
with cell[i] do
for j:=2 to 100 do
begin
calc_step(i);
angle[j]:=angle[j-1]+step_ang*sign;
x[j]:=x[j-1]+step_len*cos(angle[j]*pi/180);
y[j]:=y[j-1]+step_len*sin(angle[j]*pi/180);
end;
end;
procedure print_coord;
var i, j, k : word;
f : text;
begin
for i:=1 to 30 do
with cell[i] do
for j:=1 to 100 do
begin
writeln(i:5,x[j]:9:2,y[j]:9:2);
if j mod 20 = 0 then readln(k);
end;
end;
procedure speed_meas;
var
i,j : word;
z : real;
shift : array[1..30] of real;
begin
clrscr;
for i:=1 to 30 do shift[i]:=0;
for i:=1 to 30 do
with cell[i] do
for j:=2 to 100 do
begin
z:=sqrt((x[j]-x[j-1])*(x[j]-x[j-1])+(y[j]-y[j-1])*(y[j]-y[j-1]));
shift[i]:=shift[i]+z;
end;
for i:=1 to 30 do
begin shift[i]:=shift[i]/100;
end;
end;
procedure write_shift;
var i, j, k : word;
z : real;
shift : array[1..30] of real;
f : text;
begin
assign(f,'treck.txt');
rewrite(f);
for j:=1 to 30 do shift[j]:=0;
j:=2;
repeat
j:=j+1;
write(f,j:3);
for i:=1 to 30 do
with cell[i] do
begin
z:=sqrt((x[j]-x[j-1])*(x[j]-x[j-1])+(y[j]-y[j-1])*(y[j]-y[j-1]));
shift[i]:=shift[i]+z;
write(f,shift[i]:9:2);
end;
writeln(f);
until j=100;
close(f);
end;
procedure write_angle;
var i, j, k : word;
z : real;
shift : array[1..30] of real;
f : text;
begin
assign(f,'angle.txt');
rewrite(f);
with step_distri[angle] do
for j:=0 to 10 do writeln(f,step[j]:10:2,cent[j]:10,cummulate[j]:10);
close(f);
end;
procedure write_disp;
var i, j, k : word;
z : real;
shift, loc_calc : array[1..30] of real;
f : text;
begin
assign(f,'disper.txt');
rewrite(f);
for j:=1 to 30 do begin loc_calc[j]:=0; shift[j]:=0; end;
j:=1;
repeat
j:=j+1;
write(f,ln(j):10:2);
for i:=1 to 30 do
with cell[i] do
begin
loc_calc[i]:=0;
for k:=j+1 to 100 do
begin
z:=(x[k]-x[k-j])*(x[k]-x[k-j])+(y[k]-y[k-j])*(y[k]-y[k-j]);
loc_calc[i]:=loc_calc[i]+z;
end;
shift[i]:=loc_calc[i]/(100-j);
write(f,0.5*ln(shift[i]):10:2);
end;
writeln(f);
until j=98;
close(f);
end;
procedure write_distr;
var i, j, k : word;
z : word;
shift : array[0..35] of word;
f : text;
begin
assign(f,'dist_sp.txt');
rewrite(f);
for j:=0 to 35 do shift[j]:=0;
for i:=1 to 30 do
with cell[i] do
begin
for j:=2 to 100 do
begin
z:=round(sqrt((x[j]-x[j-1])*(x[j]-x[j-1])+(y[j]-y[j-1])*(y[j]-y[j-1])));
shift[z]:=shift[z]+1;
end;
end;
for j:=0 to 30 do writeln(f,j:3,shift[j]:10);
close(f);
end;
procedure draw_cell(c : cell_typ; x, y : real);
var
color, graph_x, graph_y : integer;
begin
case c of
slow : color:=lightcyan;
mean : color:=yellow;
fast : color:=white;
end;
graph_x:=round(x*n_pix_inline/2000);
graph_y:=round(y*n_line/2000);
putpixel(graph_x,graph_y,color);
end;
procedure draw_picture;
var
i,j : word;
begin
for i:=1 to 30 do
with cell[i] do
for j:=1 to 100 do
begin
draw_cell(speed,x[j],y[j]);
end;
end;
begin
randomize;
init;
make_all_steps;
speed_meas;
write_shift;
write_distr;
write_disp;
write_angle;
opengraph;
draw_picture;
key:=readkey;
closegraph;
end.








